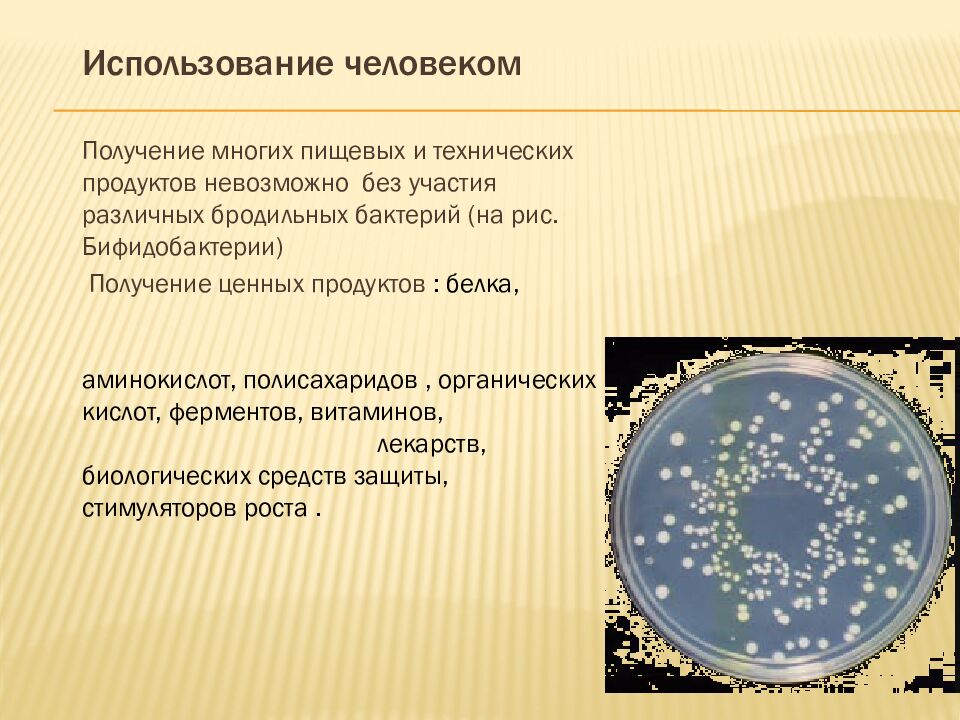
презентация: Тема: «ВИДЫ БАКТЕРИЙ»
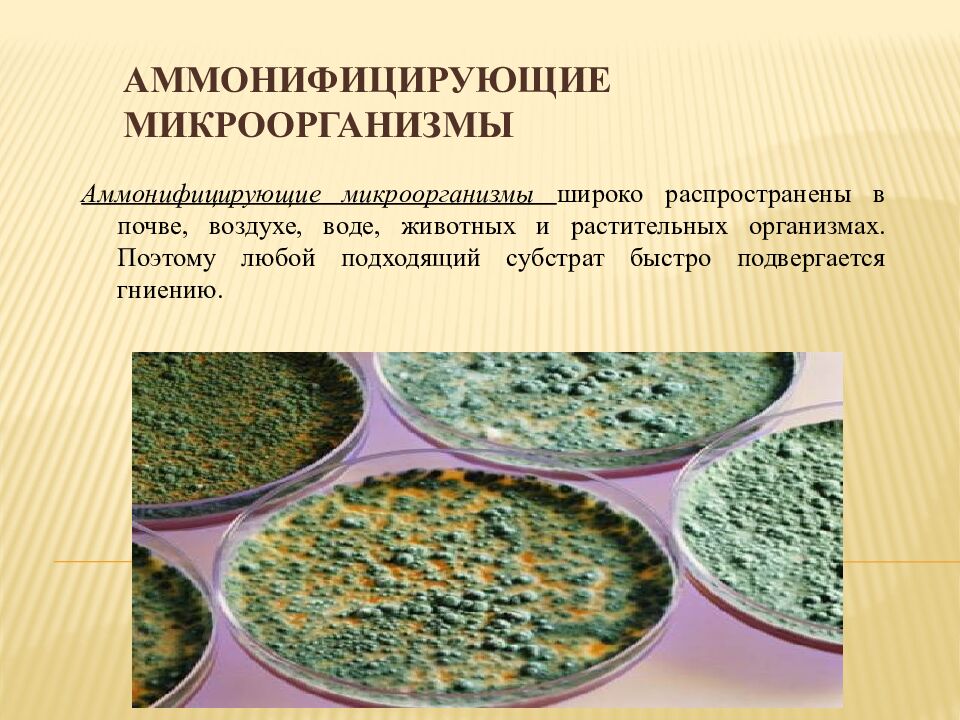
Аммонифицирующие микроорганизмы

Первый слайд презентации: презентация: Тема: «ВИДЫ БАКТЕРИЙ»
Составила: преподаватель Муратова Л,В.
Слайд 2: ВИДЫ БАКТЕРИЙ
В основном бактерии относятся к прокариотам. Это самые простые, наиболее мелкие и широко распространенные организмы. Вместе с тем имеющие способность постоянно развиваться. Бактерии настолько отличаются от других живых организмов, что их выделяют в особое царство.
А.Монотрихи - имеют один полярный жгутик. В.Лофотрихи - имеют полярно расположенный пучок жгутиков. С.Амфитрихи - имеют жгутики по диаметрально противоположным полюсам. D. Перитрихи - имеют жгутики по всему периметру бактериальной клетки.
Слайд 5
Почти все натуральные, необработанные пищевые продукты— мясо, рыба, овощи, фрукты, молоко — не могут храниться длительное время при комнатной температуре и через несколько дней, а иногда и часов продукты портятся и становятся несъедобными. Главной причиной порчи всех пищевых продуктов является жизнедеятельность микроорганизмов, или микробов.
Слайд 6
Микробы — это мельчайшие живые организмы, видимые только под микроскопом. Чаще всего это одноклеточные организмы, встречающиеся иногда в виде скоплений (колоний). Размеры отдельных микробов исчисляются обычно несколькими микронами.
Слайд 7
Существуют десятки тысяч видов разнообразных микроорганизмов. Все они отличаются друг от друга по величине, форме, размерам, строению, подвижности, отношению к внешней среде (температуре, влажности и т. д.), характеру питания и дыхания
Слайд 8: Бактерии – « великие могильщики природы » Луи Пастер
В природе бактерии встречаются повсюду, и выполняют на планете гигантскую работу. Эти маленькие организмы совершают глобальный круговорот веществ в природе, а также стоят на службе у человека.
Слайд 9: Роль в природе
А) Бактерии разрушают органические остатки, играя ведущую роль в круговороте веществ. Б) Бактерии – симбионты (кишечная палочка), поселяясь в пищеварительном тракте у животных, расщепляют целлюлозу до глюкозы, и обеспечивает усвоение этих веществ организмом животных, производят витамины и другие вещества. В) Азотфиксирующие (клубеньковые) бактерии способствуют усвоению почвенного азота корнями растений.
Слайд 10
Получение многих пищевых и технических продуктов невозможно без участия различных бродильных бактерий (на рис. Бифидобактерии ) Получение ценных продуктов : белка, аминокислот, полисахаридов, органических кислот, ферментов, витаминов, лекарств, биологических средств защиты, стимуляторов роста. Использование человеком
Слайд 11: Отрицательная роль бактерий
Различные виды гнилостных бактерий вызывают порчу пищевых продуктов. Сальмонеллез, ботулизм, холера дизентерия, являются заболеваниями, связанными с употреблением испорченных продуктов.
Слайд 12: Гниение
Гние́ние (аммонификация) — процесс разложения азотсодержащих органических соединений (белков, аминокислот), в результате их ферментативного гидролиза под действием аммонифицирующих микроорганизмов с образованием токсичных для человека конечных продуктов — аммиака, сероводорода, а также первичных и вторичных аминов при неполной минерализации продуктов разложения. Гниение
Слайд 13: Аммонифицирующие микроорганизмы
Аммонифицирующие микроорганизмы широко распространены в почве, воздухе, воде, животных и растительных организмах. Поэтому любой подходящий субстрат быстро подвергается гниению.
Слайд 14: Процесс гидролиза белка можно представить в виде следующей схемы:
белок - пептоны- полипептиды - аминокислоты.
Слайд 15
Аминокислоты подвергаются дальнейшему расщеплению, в результате чего образуются различные продукты гниения, многие из которых характеризуются неприятным запахом (аммиак, сероводород, индол, скатол, меркаптаны и др.).
Слайд 16
Чаще других гниение вызывают следующие аэробные бактерии: бациллус субтилис (сенная палочка) и бациллус мезентерикус (картофельная палочка ).
Слайд 17
Наиболее распространенными и активными возбудителями гниения в анаэробных условиях являются бациллус путрификус и бациллус спорогенес.
Слайд 18
Среди факультативных анаэробов разложение белка вызывает протеус вульгарис ( протей ).
Слайд 19
В гнилостных процессах нередко участвует бактериум коли (кишечная палочка).
Слайд 22
Бациллюс субтилис ( Bacillus subtilis ) — действующее вещество некоторых лекарственных препаратов. Показания к применению бациллюс субтилис : острые кишечные инфекции у детей дисбактериоз кишечника различной природы бактериальный вагиноз
Слайд 26
Приготовление микропрепаратов и наблюдение микроорганизмов Для приготовления микропрепарата для наблюдения в живом состоянии кусочек плесени нужно тщательно расщепить препаровальной иглой в капле воды, тогда хорошо будут видны отдельные гифы.